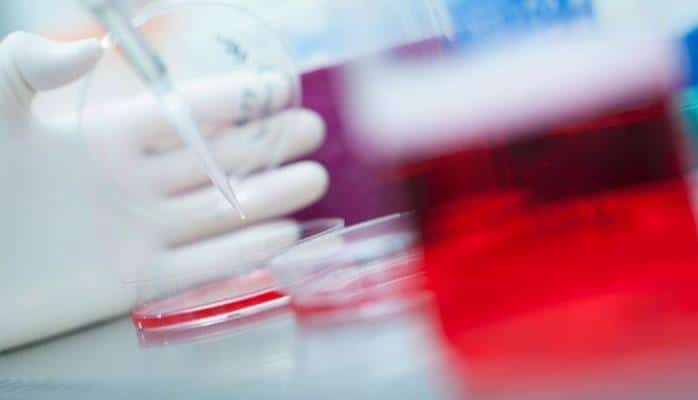
Xərçəngi sağaldan bu bitki Azərbaycanın hər yerində bitir

Müəllif: Gunel Mammadova
Müəllif: Gunel Mammadova
Müəllif: izzet qurbanov
Müəllif: Gunel Mammadova
Müəllif: Leyla Tagiyeva
Müəllif: Gunel Mammadova